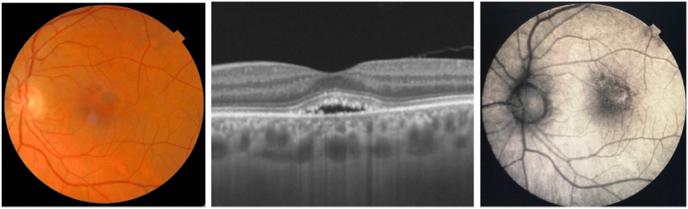

黄热病继发单侧急性特发性黄斑病变:一例报告
Unilateral acute idiopathic maculopathy secondary to yellow fever disease: a case report.
作者信息
Dompieri Rodrigo Crispim, Manzano Roberta Pereira de Almeida, Frazão Maria Auxiliadora Monteiro, Kurimori Helena Yuri, Chao John Chii Tyng, Lui Aline Cristina Fioravanti
机构信息
Irmandade da Santa Casa de Misericórdia de São Paulo, Rua Cesário Mota Júnior 112, São Paulo, São Paulo, Brazil.
出版信息
Am J Ophthalmol Case Rep. 2019 May 9;15:100464. doi: 10.1016/j.ajoc.2019.100464. eCollection 2019 Sep.
PURPOSE
To report a case of unilateral acute idiopathic maculopathy (UAIM) associated with yellow fever.
OBSERVATIONS
A 59-year-old man presented with acute blurring of his vision 30 days after symptoms of yellow fever virus infection. Findings resembling unilateral acute idiopathic maculopathy of the left eye were noted on ophthalmoscopy, fluorescein angiography and optical coherence tomography. The right eye exam was normal. He was managed conservatively and recovered complete visual function in 8 weeks.
CONCLUSIONS
We describe a case of unilateral acute idiopathic maculopathy disease in a patient infected by yellow fever virus confirmed with reverse transcriptase polymerase chain reaction (RT-PCR).
目的
报告一例与黄热病相关的单侧急性特发性黄斑病变(UAIM)病例。
观察结果
一名59岁男性在出现黄热病病毒感染症状30天后出现急性视力模糊。眼科检查、荧光素血管造影和光学相干断层扫描发现左眼有类似单侧急性特发性黄斑病变的表现。右眼检查正常。患者接受保守治疗,8周后恢复了完全的视觉功能。
结论
我们描述了一例经逆转录聚合酶链反应(RT-PCR)确诊为黄热病病毒感染患者的单侧急性特发性黄斑病变病例。